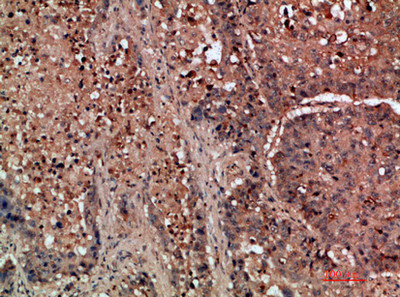

DDR2 Antibody
-
中文名稱:DDR2兔多克隆抗體
-
貨號:CSB-PA365384
-
規格:¥1090
-
圖片:
-
其他:
產品詳情
-
Uniprot No.:
-
基因名:
-
別名:CD167 antigen-like family member B antibody; CD167b antibody; CD167b antigen antibody; Cell migration inducing protein 20 antibody; DDR 2 antibody; DDR2 antibody; DDR2_HUMAN antibody; Discoidin domain containing receptor 2 antibody; Discoidin domain receptor 2 antibody; Discoidin domain receptor family member 2 antibody; discoidin domain receptor tyrosine kinase 2 antibody; Discoidin domain-containing receptor 2 antibody; discoidin domain-containing receptor tyrosine kinase 2 antibody; Hydroxyaryl protein kinase antibody; MIG20a antibody; Migration inducing gene 16 protein antibody; Neurotrophic tyrosine kinase antibody; Neurotrophic tyrosine kinase receptor related 3 antibody; NTRKR 3 antibody; NTRKR3 antibody; Receptor protein tyrosine kinase TKT antibody; Receptor protein-tyrosine kinase TKT antibody; Receptor related 3 antibody; receptor-related 3 antibody; TKT antibody; TYRO 10 antibody; TYRO10 antibody; Tyrosine kinase receptor related to neurotrophic TRK antibody; Tyrosine protein kinase TYRO 10 antibody; Tyrosine protein kinase TYRO10 antibody; Tyrosine-protein kinase TYRO10 antibody; Tyrosylprotein kinase antibody
-
宿主:Rabbit
-
反應種屬:Human,Mouse
-
免疫原:Synthetic peptide from Human protein at AA range: 31-80
-
免疫原種屬:Homo sapiens (Human)
-
標記方式:Non-conjugated
-
純化方式:The antibody was affinity-purified from rabbit serum by affinity-chromatography using specific immunogen.
-
濃度:It differs from different batches. Please contact us to confirm it.
-
保存緩沖液:Liquid in PBS containing 50% glycerol, 0.5% BSA and 0.02% sodium azide.
-
產品提供形式:Liquid
-
應用范圍:IHC,ELISA
-
推薦稀釋比:
Application Recommended Dilution IHC IHC-p:1:50-300 ELISA 1:10000-20000 -
Protocols:
-
儲存條件:Upon receipt, store at -20°C or -80°C. Avoid repeated freeze.
-
貨期:Basically, we can dispatch the products out in 1-3 working days after receiving your orders. Delivery time maybe differs from different purchasing way or location, please kindly consult your local distributors for specific delivery time.
-
用途:For Research Use Only. Not for use in diagnostic or therapeutic procedures.
相關產品
靶點詳情
-
功能:Tyrosine kinase involved in the regulation of tissues remodeling. It functions as cell surface receptor for fibrillar collagen and regulates cell differentiation, remodeling of the extracellular matrix, cell migration and cell proliferation. Required for normal bone development. Regulates osteoblast differentiation and chondrocyte maturation via a signaling pathway that involves MAP kinases and leads to the activation of the transcription factor RUNX2. Regulates remodeling of the extracellular matrix by up-regulation of the collagenases MMP1, MMP2 and MMP13, and thereby facilitates cell migration and tumor cell invasion. Promotes fibroblast migration and proliferation, and thereby contributes to cutaneous wound healing.
-
基因功能參考文獻:
- Our data indicate that DDR2 is a potent biomarker that can be used as an effective therapeutic target for treating oral squamous cell carcinoma patients with lymph node metastasis. PMID: 29945346
- DDR2 localisation is independent of integrin activation and the key DDR2 signalling effector SHC1. Structure-function analysis reveals that DDR2 mutants defective for collagen binding or kinase activity are unable to localise to the cell surface, demonstrating for the first time that both collagen binding and kinase functions are required for spatial localisation of DDR2. PMID: 29709482
- report the identification and characterization of a selective, extracellularly acting small molecule inhibitor (WRG-28) of DDR2 that uniquely inhibits receptor-ligand interactions via allosteric modulation of the receptor. By targeting DDR2, WRG-28 inhibits tumor invasion and migration PMID: 30061414
- Our results suggest that a mutation in DDR2 occurs naturally with a frequency of about 2% in Korean lung SCC patients. In addition, we showed that each of the novel DDR2 mutations were located in a kinase domain and induced an increase in cell proliferation rate. PMID: 28161936
- Overexpression of DDR2 might contribute to tumor progression in lung SQCC. The overexpression of DDR2 could be potential molecular target of lung SQCC. PMID: 28676216
- DDR2 overexpression is independently associated with tumor progression and poor survival rates in urothelial carcinoma patients. PMID: 27793038
- The DDR2 E655K mutation can play a role in cancer progression. PMID: 26826182
- collagen II-activated phosphorylated-DDR2 induces CYR61 through activation of transcription factor activator protein 1 (AP-1). The elevated CYR61, in turn, accelerates MMP1 production via ETS1 (ETS proto-oncogene 1). PMID: 27653023
- these data suggest that biological collagen aging could increase tumor cell proliferation by reducing the activation of the key matrix sensor DDR2 PMID: 27121132
- Female ddr2-deficient mice homozygous for the slie mutation show inefficient spontaneous BC metastasis. PMID: 28147276
- This study suggested that DDR1 and DDR2 knockdown alters brain immunity and significantly reduces the level of triggering receptor expressed on myeloid cells (TREM)-2 and microglia. PMID: 28863860
- This work identifies DDR2 as a potential therapeutic target that controls breast cancer metastases through its action in both tumor cells and tumor-stromal cells at the primary tumor site. PMID: 27264173
- The group of patients with colorectal cancer with high DDR2 expression had significantly higher frequencies of T4, lymph node metastasis, and peritoneal dissemination compared to the group with low DDR2 expression. PMID: 28476831
- DDR2 showed high expression in gastric cancer tissues and cells. In xenograft models, DDR2 overexpression promoted tumor formation. Furthermore, DDR2 expression impacted on the invasion and motility of GC cells, accompanied by changes in EMT marker expression. Finally, our results revealed that DDR2 facilitates GC cell invasion and EMT through mTORC2 activation and AKT phosphorylation. PMID: 27010547
- DDR2 mediates collagen-induced activation of MT1-MMP in human fibroblasts PMID: 28270508
- Study strongly suggests that during pulmonary fibrosis, DDR2 not only participates in both the initiation and maintenance of fibrotic reaction, but also affects both ECM production and angiogenesis. PMID: 27350126
- signaling pathway, effectively suppressed peritoneal dissemination. DDR2 was identified as a driver gene for Gastric Cancer dissemination from the combined expression signature and can potentially serve as a novel therapeutic target for inhibiting Gastric Cancer peritoneal dissemination. PMID: 26934957
- DDR2 Missense mutation is associated with spondylo-meta-epiphyseal dysplasia, short limb-abnormal calcification type. PMID: 26463668
- Data suggest SCl2 (Streptococcus pyogenes) binds to DDR (DDR1, DDR2) ectodomain w/o stimulating receptor signaling; here, protein engineering was used to construct SCl-like proteins that inhibit collagen-DDR interactions and macrophage migration. PMID: 26702058
- DDR2 plays an important role in promoting hepatocellular carcinoma cell invasion and migration by stabilizing SNA1. PMID: 26362312
- The inhibition of DDR2 by RNA interference suppressed in vivo and in vitro growth of human hepatocellular carcinoma cells. PMID: 25842034
- Report correlation between increased radiographic grade of knee osteoarthritis and decreased proportion of cartilage stained for DDR2. PMID: 26191278
- Identified are 3 Single Nucleotide Polymorphisms in DDR2 significantly associated with hip bone mineral density in the Chinese population. PMID: 25658585
- Defective Ca(2+) binding in a conserved binding site causes incomplete N-glycan processing and endoplasmic reticulum trapping of DDR1 and DDR2 receptors. PMID: 25470979
- Data show that discoidin domain receptor 2 (DDR2) is linked to a polyubiquitin (Ub) chain predominantly through lysine K27 conjugation and slightly through K33. PMID: 26271983
- In ADSCC patients, DDR2 mutation coexisted with G12C substitution in KRAS gene. PMID: 25173530
- peptide delivered by the AuNP-Apt system inhibited cancer cell proliferation and invasion mediated by DDR2 activation PMID: 26067556
- A DDR1(Low)/DDR2(High) protein profile is associated with TNBC and may identify invasive carcinomas with worse prognosis. PMID: 25667101
- DDR2 signaling regulates cell proliferation and extracellular matrix synthesis, which are key aspects of fibroblast contribution to tissue healing [review] PMID: 24781958
- DDR2 promoted chondrocyte hypertrophy and terminal differentiation. PMID: 24938620
- DDR2 plays an important role in head and neck squamous cell carcinoma metastasis, and might be a promising target for future therapies in this type of cancer. PMID: 24556606
- These data indicated that the novel DDR2 mutation may contribute to the development and progression of lung SCC and this effect may be associated with increased proliferation and invasiveness, at least in part, via regulating E-cadherin expression. PMID: 24885564
- Our results highlight potential RTK-driven adaptive-resistant mechanisms upon DDR2 targeting, and they suggest new, rationale cotargeting strategies for DDR2-mutant lung squamous cell cancer PMID: 25348954
- Promising therapeutic opportunities based on existing and novel targeted small molecule inhibitors against DDR2 may provide new strategies for treating lung squamous cell cancer patients. PMID: 24828669
- High DDR2 protein expression is associated with recurrence in ameloblastomas. PMID: 24723326
- we conclude that DDR2 participates in hypoxia-induced breast cancer metastasis through the regulation of cell migration, invasion, and epithelial-mesenchymal transition PMID: 25130389
- In this review we highlight the mechanisms whereby DDRs(DDR1 and DDR2) regulate two important processes, namely inflammation and tissue fibrosis. PMID: 24361528
- DDR2 overexpression is associated with neoplasms. PMID: 24740739
- Whole genome analyses of a well-differentiated liposarcoma reveals novel SYT1 and DDR2 rearrangements. PMID: 24505276
- Discoidin domain receptor 2 facilitates prostate cancer bone metastasis via regulating parathyroid hormone-related protein. PMID: 24787381
- Cbl-b, by promoting the ubiquitination and degradation of DDR2, functions as a negative regulator in the DDR2 signaling pathway. PMID: 24631539
- A novel missense deletion mutation in DDR2 causing spondylo-meta-epiphyseal dysplasia with short limbs and abnormal calcifications (SMED-SL) results in defective intra-cellular trafficking. PMID: 24725993
- regulation of DDRs by glucose PMID: 24018687
- Loss of DDR2 suppresses tumor angiogenesis and tumor metastasis to the lung. PMID: 24293323
- SHP-2 is a key signalling node downstream of the DDR2 receptor in lung cancer. PMID: 23822953
- DDR2 functioning is required for the membrane dynamics to control the mechanical attachment of fibroblasts to the 3D collagen matrices in an integrin-independent manner. PMID: 23546533
- DDR2 maintains SNAIL1 level and activity in tumour cells that have undergone epithelial-mesenchymal transition (EMT), thereby facilitating continued tumour cell invasion through collagen-I-rich extracellular matrices by sustaining the EMT phenotype. PMID: 23644467
- DDR2 is an independent favorable predictor for prognosis in human breast cancer. PMID: 23307244
- Mutations in the DDR2 gene were recently identified in squamous cell lung cancer through a sequencing screen of 201 genes with a potential role in human cancer (including the entire tyrosine kinome). PMID: 23401445
- DDR2 regulates directionality through its ability to increase secretion of metalloproteinases and local generation of collagen-derived chemotactic peptide gradients. PMID: 23233663
顯示更多
收起更多
-
相關疾病:Spondyloepimetaphyseal dysplasia short limb-hand type (SEMD-SL)
-
亞細胞定位:Cell membrane; Single-pass type I membrane protein.
-
蛋白家族:Protein kinase superfamily, Tyr protein kinase family, Insulin receptor subfamily
-
組織特異性:Detected in osteocytes, osteoblastic cells in subchondral bone, bone lining cells, tibia and cartilage (at protein level). Detected at high levels in heart and lung, and at low levels in brain, placenta, liver, skeletal muscle, pancreas, and kidney.
-
數據庫鏈接:
Most popular with customers
-
-
YWHAB Recombinant Monoclonal Antibody
Applications: ELISA, WB, IHC, IF, FC
Species Reactivity: Human, Mouse, Rat
-
Phospho-YAP1 (S127) Recombinant Monoclonal Antibody
Applications: ELISA, WB, IHC
Species Reactivity: Human
-
-
-
-
-